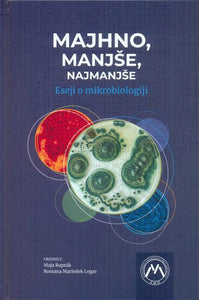

528 rezultatov
-

-

-
 Animal Reiki: Using Energy to Heal the Animals in Your Life(2006) ELIZABETH FULTONVezava: Mehka23,82 €
Animal Reiki: Using Energy to Heal the Animals in Your Life(2006) ELIZABETH FULTONVezava: Mehka23,82 € -
 Blue Mind - How Water Makes You Happier, More Connected and Better at What You Do(2018) WALLACE J. NICHOLSVezava: Mehka18,21 €
Blue Mind - How Water Makes You Happier, More Connected and Better at What You Do(2018) WALLACE J. NICHOLSVezava: Mehka18,21 € -

-
 Parrots of the Wild: A Natural History of the World� s Most Captivating Birds(2015) CATHERINE A. TOFTVezava: Trda61,40 €
Parrots of the Wild: A Natural History of the World� s Most Captivating Birds(2015) CATHERINE A. TOFTVezava: Trda61,40 € -

-